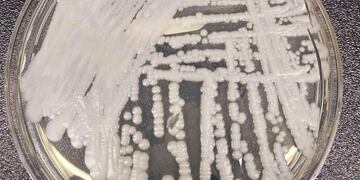
Cepa de candida auris cultivada en un laboratorio. Ya hay dos casos en Argentina.

Vía Resistencia
Una joven chaqueña denunció que su mamá estaba desaparecida, pero la encontraron muerta en su casa
Las autoridades policiales ingresaron a la vivienda el domingo y encontraron el cuerpo de la mujer, quien habría sido asesinada a puñaladas hace una semana. La hija de la víctima y su novio están detenidos y la investigación continúa.